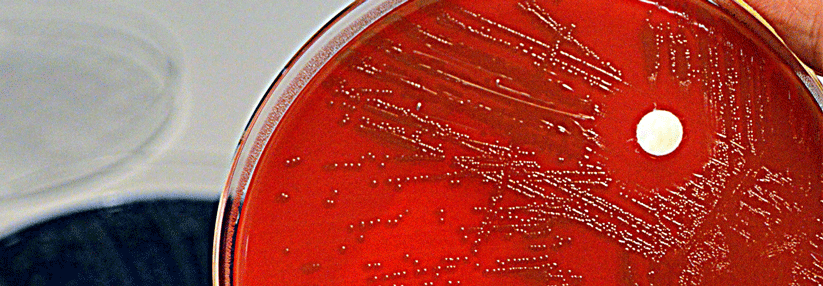

Argumente gegen Impfskepsis: Ein Pädiater widerlegt sieben Mythen zu Impfungen
 Die heutigen Impfstoffe sind wesentlich besser verträglich als die früher verwendeten Vakzinen.
© iStock.com/undefined undefined
Die heutigen Impfstoffe sind wesentlich besser verträglich als die früher verwendeten Vakzinen.
© iStock.com/undefined undefined
Mythos 1: Impfungen sind heute nicht mehr erforderlich
Vor allem Impfgegner behaupten immer wieder, dass ehemals häufige Infektionserkrankungen wie Diphtherie, Tetanus und Poliomyelitis aufgrund der guten Lebensbedingungen verschwunden seien oder unkompliziert verliefen. Tatsächlich haben nicht die Lebensumstände, sondern die öffentlichen Impfprogramme die Inzidenz verringert. Eradizieren lassen sich Infektionskrankheiten nur durch anhaltend hohe Durchimpfungsraten. Gelungen ist dies bisher nur bei den Pocken. Auch bei Masern und Poliomyelitis wäre eine Eradikation problemlos möglich, wenn sich genügend Personen impfen ließen, schreibt Professor Dr. Fred Zepp von der Universitätsmedizin Mainz.
Mythos 2: Eine Krankheit selbst durchzumachen, schützt besser als eine Impfung
Mit diesem Argument veranstalten impfkritische Eltern sogenannte „Masernpartys“. Sie unterschätzen dabei, dass die Maserninfektion ein weitaus höheres Risiko birgt als die Impfung: Eins von tausend infizierten Kindern entwickelt eine Enzephalitis, nicht selten mit bleibenden neurologischen Schäden. Auch Jahre nach der Erkrankung kann es noch zu einer subakuten sklerosierenden Panenzephalitis (SSPE) kommen, die immer tödlich verläuft. Beide Erkrankungen lassen sich mit der Vakzination verhindern.
Mythos 3: Impfrisiken und Nebenwirkungen sind nicht hinreichend bekannt
Auch diese Behauptung ist falsch. Wirksamkeit und Sicherheit der heute genutzten Impfstoffe wurden in zahlreichen Studien geprüft. Außerdem sorgen obligatorische Studien nach der Zulassung dafür, dass auch seltene Nebenwirkungen erfasst werden. Dabei konnte bisher kein Zusammenhang zur Multiplen Sklerose gefunden werden. Auch der plötzliche Kindstod tritt nicht vermehrt auf. Impfnebenwirkungen beschränken sich meist auf Lokalreaktionen (Rötung, Schwellung etc.). Begleitendes Fieber ist nur ein Ausdruck für die schützende Immunantwort.
Mythos 4: Zu viele Impfungen bzw. Kombinationsimpfungen belasten das Immunsystem
Die heutigen Impfstoffe sind wesentlich besser verträglich als die früher verwendeten Vakzinen. Fortschritte der Biotechnologie ermöglichen es, exakt die Bestandteile zu isolieren, die für die erwünschte Immunantwort zuständig sind. Dadurch ließ sich die Zahl der im ersten Lebensjahr verabreichten Antigene um den Faktor 10 auf etwa 150 Antigene reduzieren. Entwarnung auch bei den als Adjuvanzien genutzten Aluminiumsalzen: Über Impfstoffe wird wesentlich weniger Aluminium aufgenommen als mit der Nahrung.
Mythos 5: Impfungen sind für Autoimmunerkrankungen verantwortlich
Für diese These gibt es keinen Beleg, betont Prof. Zepp. Alle Untersuchungen, die die Inzidenz von Autoimmunerkrankungen in geimpften und ungeimpften Populationen verglichen, konnten kein erhöhtes Risiko im Zusammenhang mit der Vakzination nachweisen.
Mythos 6: Impfungen führen zu Autismus
Mit dieser Falschinformation argumentieren Impfgegner seit Jahrzehnten. Die Hypothese beruht auf einer Studie von 1998 mit nur acht Patienten, sie sorgte aber für einen gründlichen Vertrauensverlust bei der Schutzimpfung gegen Masern, Mumps und Röteln (MMR). Die Publikation wurde inzwischen von der Zeitschrift Lancet zurückgezogen, im selben Jahr verlor der Autor wegen schwerer Verstöße gegen die Berufsordnung seine Zulassung. Eine Metaanalyse mit fast 1,3 Mio. Kindern ermittelte keine Beziehung zum Autismus. Aber die Mär vom Zusammenhang zur MMR-Impfung hat die weltweite Maserneradikation erheblich verzögert.
Mythos 7: Schwangere sollen nicht geimpft werden
Totimpfstoffe können zu jedem Zeitpunkt der Gravidität sicher verabreicht werden. Lebendimpfstoffe sind wegen des theoretischen Risikos einer diaplazentaren Übertragung bei Schwangeren kontraindiziert. Studien mit Masern-, Mumps- und/oder Rötelnvakzinen, oraler Poliovakzine und Gelbfieberimpfstoffen ergaben allerdings kein erhöhtes Risiko für Mutter und Kind. Für Schwangere ausdrücklich empfohlen wird bereits jetzt die saisonale Influenza-Impfung, zukünftig auch die dTap*-Impfung, so Prof. Zepp. Denn Tetanus, Pertussis und Influenza können bei der Frau und ihrem Ungeborenen schwere Komplikationen auslösen, die sich durch die Impfung verhindern lassen.
* Diphtherie, Tetanus, Pertussis (azellulär)
Quelle: Zepp F. Monatsschr Kinderheilkd 2018; 166: 1114-1119